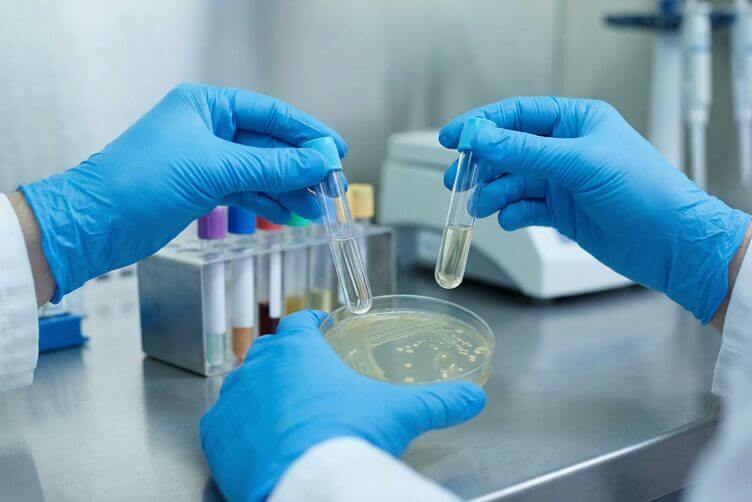
Analisi di laboratorio per approfondire disbiosi intestinale e infiammazione correlata ai sintom Analisi di laboratorio per approfondire disbiosi intestinale e infiammazione correlata ai sintom

Qual è il nesso tra intolleranza alimentare e disbiosi intestinale?
Oggi si parla spesso di intolleranze alimentari, ma raramente si approfondisce la loro connessione profonda con la disbiosi intestinale. Il legame tra ciò che mangiamo e l’equilibrio dei microrganismi che ospitiamo è molto più stretto di quanto si pensi: spesso l’una è lo specchio dell’altra.
Il nesso tra infiammazione e batteri intestinali
In molti casi, l’intolleranza nasce da una vera reazione di “tossicità” verso certi cibi. Quando un alimento non viene digerito correttamente, entra in contatto con la mucosa intestinale e può scatenare una risposta del sistema immunitario.
I sintomi non sono sempre immediati, e questo rende difficile individuare la causa. Possiamo distinguere tra:
- Sintomi intestinali: Diarrea, gonfiore addominale, nausea o crampi.
- Sintomi extra-intestinali: Stanchezza cronica, mal di testa, nebbia mentale o disturbi cutanei (come acne o dermatiti).
La disbiosi — ovvero l’alterazione dell’equilibrio della flora batterica — funge spesso da “moltiplicatore”. Un microbiota impoverito o sbilanciato non riesce a scindere correttamente le molecole alimentari, aumentando la probabilità di reazioni avverse e infiammazioni croniche.
Intolleranza alimentare e disbiosi intestinale: meglio saperne di più!
Per capire la disbiosi, dobbiamo visualizzare il nostro intestino come un ecosistema complesso. Ognuno di noi convive con miliardi di microrganismi: si stima che nel nostro corpo alberghino circa $10^{15}$ batteri, ovvero dieci volte il numero delle cellule che compongono l’intero organismo umano.
Questi microrganismi costituiscono il microbiota intestinale, un vero e proprio “super-organo” che vive in simbiosi con noi. Quando siamo in equilibrio (stato di eubiosi), i batteri ci aiutano a digerire, producono vitamine e proteggono il sistema immunitario. Quando questo equilibrio si rompe a causa di stress, farmaci o diete squilibrate, entriamo in uno stato di disbiosi.
Consiglio: Il consumo eccessivo di cibi raffinati e zuccheri è uno dei principali nemici del microbiota. Prediligere alimenti poco raffinati e naturali è il primo passo per prenderci cura della nostra salute fisica e psicologica.
Disbiosi intestinale in gravidanza: un rischio da non sottovalutare
La salute dell’intestino materno è cruciale per lo sviluppo del nascituro. Studi recenti confermano che il feto entra in contatto con i microrganismi materni già durante la gestazione, influenzando il suo futuro sistema immunitario.
Gli effetti sul bambino
- In caso di Eubiosi (Equilibrio): Il neonato trae beneficio dal contatto con i batteri materni sani, costruendo difese forti.
- In caso di Disbiosi (Squilibrio): Il neonato è esposto a ceppi batterici che potrebbero aumentare la predisposizione a malattie come diabete infantile, allergie e obesità.
I rischi per la futura mamma
Una flora batterica alterata favorisce un maggiore assorbimento di calorie, rendendo difficile il controllo del peso e aumentando il rischio di sviluppare il diabete gestazionale. Inoltre, la disbiosi può essere concausa di cistiti, candidosi vaginale e disturbi dell’umore come ansia e depressione.
Cosa fare quando si sospetta un’intolleranza alimentare?
Se sospetti che un alimento ti faccia male, la regola d’oro è: evita il “fai-da-te”. Iniziare da soli una dieta di esclusione drastica può creare squilibri nutrizionali e stressare ulteriormente un microbiota già fragile.
Il percorso ideale prevede:
- Diagnosi Accurata: Affidati a test con validità scientifica per capire se i sintomi sono legati a un’intolleranza, alla sindrome del colon irritabile o a patologie più complesse come il morbo di Crohn.
- Supporto Professionale: Un nutrizionista esperto può aiutarti a impostare un piano alimentare che tolga l’infiammazione senza privarti dei nutrienti essenziali.
- Diario Alimentare: Uno strumento prezioso per annotare cosa mangi e come ti senti, aiutando il medico a trovare il nesso causa-effetto.
Menù tipo: Una giornata per il tuo microbiota
Per aiutarti a visualizzare come si mangia per “sfiammare” l’intestino, ecco un esempio di giornata alimentare ispirata alla cucina di Nonna Paperina, pensata per essere leggera, gustosa e amica dei batteri buoni.
| Pasto | Piccolo suggerimento |
|---|---|
| Colazione | Latte di mandorla (senza zucchero) con pancake di grano saraceno e mirtilli freschi. |
| Pranzo | Riso integrale o Venere saltato con zucchine, carote e un pizzico di curcuma. Proteina: Petto di pollo bio o tacchino al vapore. |
| Spuntino | Una mela cotta con cannella (ottima fonte di pectina per riparare la mucosa). |
| Cena | Vellutata di zucca con semi di zucca tostati e filetto di orata al cartoccio con erbe aromatiche. |
I 3 Condimenti Amici del tuo Intestino
Non è solo cosa mangi, ma come lo condisci! Ecco tre alleati per ridurre l’infiammazione e nutrire il microbiota:
Olio Extravergine d’Oliva (a crudo): È il re della dieta mediterranea. Ricco di polifenoli, agisce come un potente antiossidante che protegge la mucosa intestinale. Usalo sempre a freddo per preservarne le proprietà.
Aceto di Mele (non pastorizzato): Se tollerato, l’aceto di mele “con la madre” aiuta a stimolare la produzione di acido cloridrico nello stomaco, migliorando la digestione delle proteine e prevenendo le fermentazioni intestinali.
Gomasio (Semi di sesamo e sale): Un’ottima alternativa al solo sale. I semi di sesamo apportano calcio e grassi buoni, mentre la presenza del sale marino integrale in piccole quantità aiuta l’equilibrio elettrolitico senza irritare le pareti gastriche.
FAQ su Disbiosi e Intolleranze
Quali sono i principali sintomi che distinguono disbiosi da intolleranze?
La disbiosi dà spesso gonfiore costante, alvo irregolare e stanchezza. Le intolleranze provocano disturbi più specifici legati al consumo di certi alimenti (dolori addominali, reazioni cutanee immediate o differite).
Come si modifica il microbiota in caso di intolleranza alimentare?
Quando un alimento crea infiammazione, la varietà batterica diminuisce. Alcuni batteri utili scompaiono, lasciando spazio a specie opportuniste che peggiorano la digestione.
Quali alimenti favoriscono un microbiota equilibrato?
Frutta, verdura di stagione, cereali integrali e legumi (se ben tollerati). Anche i cibi fermentati come yogurt senza lattosio o kefir possono aiutare, previa valutazione della tollerabilità individuale.
Come intervenire con i probiotici?
I probiotici non sono tutti uguali. Vanno scelti con l’aiuto di un professionista in base al tipo di squilibrio riscontrato e assunti con costanza all’interno di una dieta bilanciata.